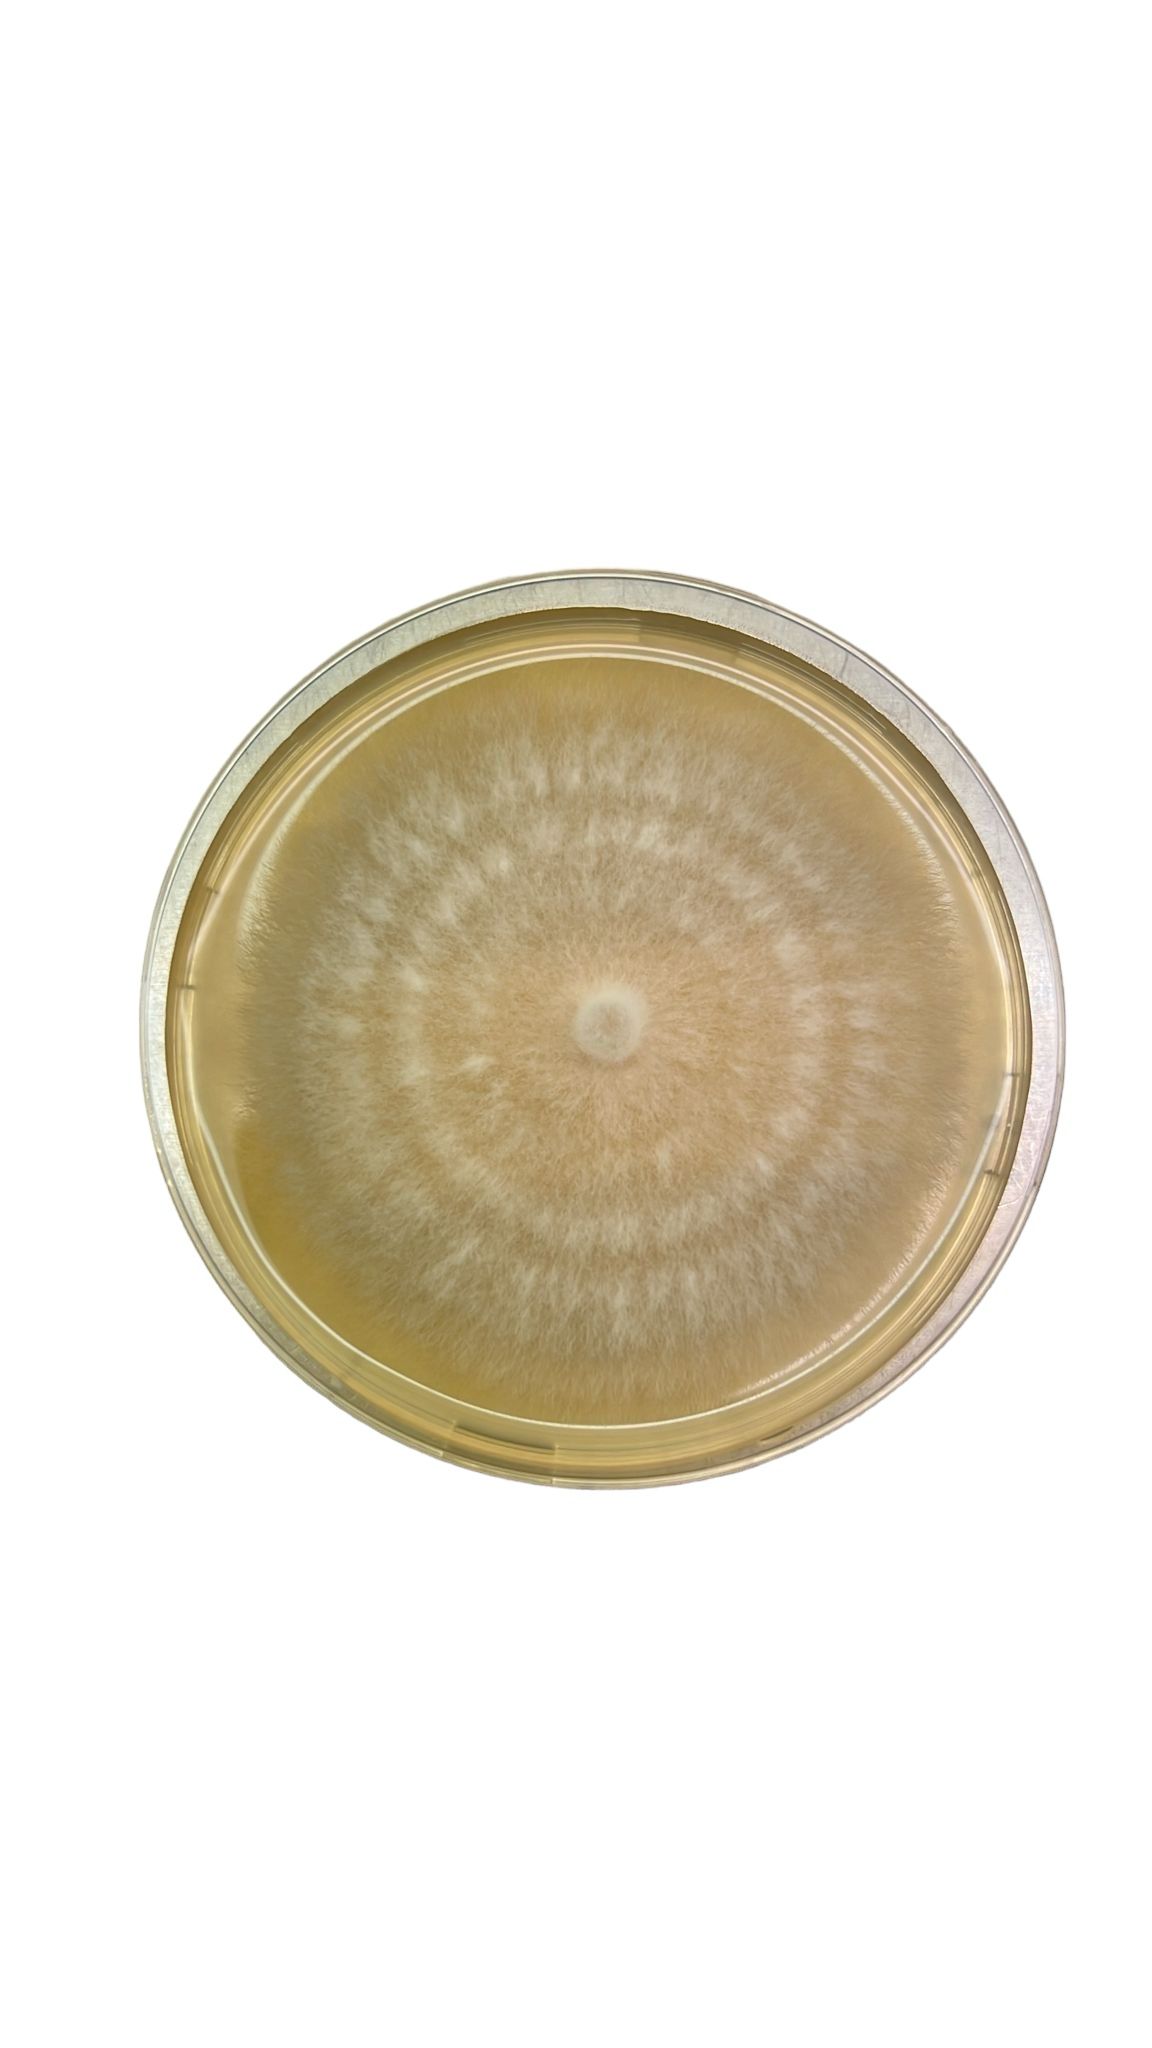

Description
Discover the Potential of the Agar Punch – A Tool with a Learning Curve!
Dimensions: 16cm long, 1cm wide. Maximum depth of cut 1 cm
The Agar Punch Transfer Tool is a tool that offers excellent potential for agar transfers and creating beautiful agar plates. While it may have a learning curve and require some practice, its handmade craftsmanship and precision design make it stand out. It’s important to handle the Agar Punch carefully, as the spring and metal insert at the back can come off easily and are not held in place. To use the tool effectively, heat the front bit in a flame, carefully transfer the mycelium onto a fresh agar plate, and delicately release it centrally and close to the agar’s surface to ensure upright positioning. Despite its initial challenges, with dedication and practice, the Agar Punch can become an invaluable tool for mycologists seeking to perfect their agar plates.
So, if you’re committed to perfecting your agar plates and don’t mind investing a bit of time and effort in mastering this tool, the Agar Punch Transfer Tool could become an invaluable addition to your mycology toolkit.
Important: This Product is not Autoclavable